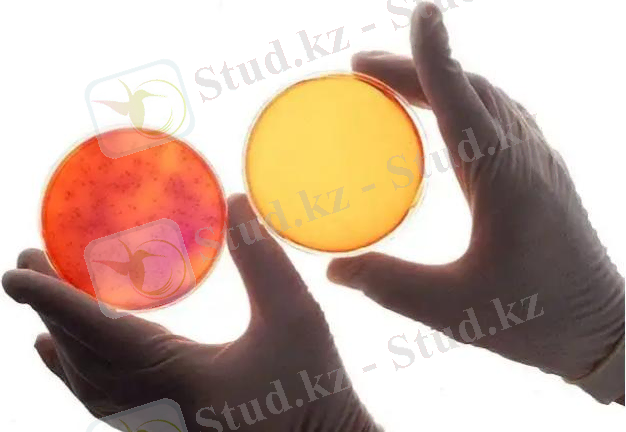

Зертханалық құрал-жабдықтар мен аспаптардың қысқаша сипаттамасы


 1. Ламинарлық бокс-
Бір-бірімен араласпайтын, белгілі бір (
сындарлы
) жылдамдыққа дейін ғана жүзеге асатын сұйықтың (
газдың
) жекелеген өте жұқа қабатшаларының немесе бір-біріне бойлас өрілген сорғаламаларының ағысы
1. Ламинарлық бокс-
Бір-бірімен араласпайтын, белгілі бір (
сындарлы
) жылдамдыққа дейін ғана жүзеге асатын сұйықтың (
газдың
) жекелеген өте жұқа қабатшаларының немесе бір-біріне бойлас өрілген сорғаламаларының ағысы
 2. Микроскоп -
Микроскоп (грек.
mіkros
-
ұсақ
және
skopeo
-
көремін
) - жай көзге көрінбейтін нысандардың (немесе олардың құрылымдыбөліктерінің) бірнеше есе үлкейтілген кескінін алатын оптикалық прибор
2. Микроскоп -
Микроскоп (грек.
mіkros
-
ұсақ
және
skopeo
-
көремін
) - жай көзге көрінбейтін нысандардың (немесе олардың құрылымдыбөліктерінің) бірнеше есе үлкейтілген кескінін алатын оптикалық прибор
3.
 CO² инкубаторы-
жасуша дақылдарының оңтайлы, ұдайы өсу жағдайларына кепілдік береді.
CO² инкубаторы-
жасуша дақылдарының оңтайлы, ұдайы өсу жағдайларына кепілдік береді.
 4
.
Центрифуга
- Сұйық және қатты фазалы суспензиялардың бөлнуі үшін қызмет істейді . Центрифуга -электродвигательдің бөлігіне үздіксіз касадкалы екі ротормен қамтамасыз етілген.
4
.
Центрифуга
- Сұйық және қатты фазалы суспензиялардың бөлнуі үшін қызмет істейді . Центрифуга -электродвигательдің бөлігіне үздіксіз касадкалы екі ротормен қамтамасыз етілген.
 5.
Дистиллятор
- суды дистилдеуге арналған қондырғы.
5.
Дистиллятор
- суды дистилдеуге арналған қондырғы.
6. Автоклавтар - ыдыстардың стерилизациялануына, қоректік ортаның және тағы басқа материялдардың қаныққан бу қысымымен атмосферадан жоғары қызмет істейді.

 7
.
Термостаттар
- берілген тұрақты температурада микроорганизмдердің қоректік ортада айналдыру үшін қолданады.
7
.
Термостаттар
- берілген тұрақты температурада микроорганизмдердің қоректік ортада айналдыру үшін қолданады.
 8. Фотоэлектроколориметр -
коллойдты және боялған ерітінділердің өткізу коэфицентін және оптикалық тығыздықтарын анықтауда қолданады.
8. Фотоэлектроколориметр -
коллойдты және боялған ерітінділердің өткізу коэфицентін және оптикалық тығыздықтарын анықтауда қолданады.
9. Спектрофотометр -
қатты және сұйық заттардың өткізу коэфиценттерін және оптикалық тығыздығын анықтауға қолданылады.

10 . Кептіргіш шкаф- лабораториялық ыдыстарды, т. б. заттарды кептіруге қолданылады.

 11
.
Аквадистиллятор
- бұл суды тазартуға арналған құрылғы. Дистилляция немесе дистилляция әдісі (латын тілінде distillatio «тамшылау» дегенді білдіреді) суды ең тиімді және жан-жақты әдісі болып саналады.
11
.
Аквадистиллятор
- бұл суды тазартуға арналған құрылғы. Дистилляция немесе дистилляция әдісі (латын тілінде distillatio «тамшылау» дегенді білдіреді) суды ең тиімді және жан-жақты әдісі болып саналады.
 12. Су деионизаторы-
D-301 - жоғары тазартылған су алуға арналған арзан, қолдануға ыңғайлы және сенімді құрылғы. Деионизатор шығыс бөлігіндегісудың кедергісін бақылайды және белгіленген режимнен ауытқу кезінде сигнал береді
12. Су деионизаторы-
D-301 - жоғары тазартылған су алуға арналған арзан, қолдануға ыңғайлы және сенімді құрылғы. Деионизатор шығыс бөлігіндегісудың кедергісін бақылайды және белгіленген режимнен ауытқу кезінде сигнал береді
 13
.
Колбалар
- зертханаларда реакциялық ыдыстар ретінде қолданылады. Аналитикалық ерітінділерді жоғары дәлдікпен дайындауға арналған арнайы көлемдік колбалар да бар.
13
.
Колбалар
- зертханаларда реакциялық ыдыстар ретінде қолданылады. Аналитикалық ерітінділерді жоғары дәлдікпен дайындауға арналған арнайы көлемдік колбалар да бар.
14. Градустық цилиндрлер - бұл сұйықтықтың көлемін өлшеуге арналған, сонымен қатар басқа ыдыстарға құюға арналған химиялық көлемді шыны ыдыстардың бір түрі.

 15. Пробиркалар -
мөлшері аз заттармен химиялық тәжірибелер жасағанда қолданылады. Оларды штативтерде сақтайды.
15. Пробиркалар -
мөлшері аз заттармен химиялық тәжірибелер жасағанда қолданылады. Оларды штативтерде сақтайды.
16. Муфельді пеш - бұл белгілі бір температураны алдын ала белгіленген, әдетте жоғары температураға дейін қыздыруға арналған жылыту құрылғысы.

17. Ареометр - сұйықтықтың меншікті салмағын немесе тығыздығын тез арада анықтауға арналған құралғы. Заттың меншікті салмағы арқылы оның ерітіндідегі пайыздық мөлшері анықталады

 18.
Эксикатор
- бұл белгілі бір ауа ылғалдылығы сақталатын, қалың шыныдан немесе пластмассадан жасалған ыдыс.
18.
Эксикатор
- бұл белгілі бір ауа ылғалдылығы сақталатын, қалың шыныдан немесе пластмассадан жасалған ыдыс.
 19. Суытқыштар -
суытуға және конденсациялауға қолданылады. Тура суытқыштар (Либих суытқышы) конденсат жинау үшін, кері суытқыштар конденсат қайта процеске қайтқан кезде қолданылады.
19. Суытқыштар -
суытуға және конденсациялауға қолданылады. Тура суытқыштар (Либих суытқышы) конденсат жинау үшін, кері суытқыштар конденсат қайта процеске қайтқан кезде қолданылады.
20. Кристаллизаторлар - сыйымдылығы мен диаметрі әр түрлі жұқа, жазық түпті шыны ыдыстар. Оларды заттарды қайта кристалдау үшін, кей кезде ерітінділерді сусыздандыру үшін қолданады. Оларды тек су моншасында ғана қыздыру қажет

21. Пикнометр - грек тілінен «тығыздық, өлшеймін» деген сөз, физика-химиялық құралғы, шыны ыдыс, қатты, газтәріздес және сұйық заттардың тығыздығын өлшеуге қолданылады. 1859 жылы Дмитрий Иванович Менделеев ойлап тапқан.

 22. Кипп аппараты -
газдарды алуға және сақтауға арналған зертханалық құралғы.
22. Кипп аппараты -
газдарды алуға және сақтауға арналған зертханалық құралғы.
 23.
Воронкалар
әр түрлі пішінді және өлшемдері әр түрлі болады. Олардың қолданылуы да әр түрлі: конус тәріздес воронкалар арқылы сұйықтарды құюға, фильтрлеуге болады. Ө
23.
Воронкалар
әр түрлі пішінді және өлшемдері әр түрлі болады. Олардың қолданылуы да әр түрлі: конус тәріздес воронкалар арқылы сұйықтарды құюға, фильтрлеуге болады. Ө
24. Кьельдаль колбасы алмұрт тәрізді, ұзын мойынды, оларды негізінен азотты анықтау үшін қолданады. Кьельдаль колбасын қиын балқитын, термотұрақты шыныдан (пирекс) жасайды.

25. Аллонждар - шыныдан жасалған иілген трубкалар, оларды айдау процесі кезінде суытқышты айдалған сұйықтықты қабылдайтын ыдыспен қосу үшін қолданады.

26. Петри ыдысы - үлгілер үшін пайдаланылады. Бұл петри ыдыстары иондаушы ауаның сальмонеллалардың өсуіне зарарсыздандыру әсерін суреттейді. Бұл петрри тағамдары салонилла бактерияларының өсуіне иондалған ауаның зарарсыздандыру әсерлерін көрсетеді.
27. Пипеткалар -
шағын көлемді өлшеуге және тасымалдауға арналған. Тамшуырлардың әр түрлі түрлері бар. Тамшует түрлерінің үлгілері бір реттік, резервтік, автоклавт
 ы және қолмен жасалады.
ы және қолмен жасалады.
28. Температураны өлшеу үшін термометр қолданылады.

29. Флакондар - . Әйнек шишалары ақ фиаллар деп аталады. Бұл шыны флаконда резеңке тығыздағыштар мен металл қақпақтар бар. Әйнек шишалары ақ фиаллар деп аталады. Бұл шыны флаконда резеңке тығыздағыштар мен металл қақпақтар бар.

30. Галилео термометрі - зертханалық жабдық. Галилео термометрі қаттылық қағидаларын қолдана отырып жұмыс істейді. Галилео термометрі қаттылық қағидаларын қолдана отырып жұмыс істейді.

- Іс жүргізу
- Автоматтандыру, Техника
- Алғашқы әскери дайындық
- Астрономия
- Ауыл шаруашылығы
- Банк ісі
- Бизнесті бағалау
- Биология
- Бухгалтерлік іс
- Валеология
- Ветеринария
- География
- Геология, Геофизика, Геодезия
- Дін
- Ет, сүт, шарап өнімдері
- Жалпы тарих
- Жер кадастрі, Жылжымайтын мүлік
- Журналистика
- Информатика
- Кеден ісі
- Маркетинг
- Математика, Геометрия
- Медицина
- Мемлекеттік басқару
- Менеджмент
- Мұнай, Газ
- Мұрағат ісі
- Мәдениеттану
- ОБЖ (Основы безопасности жизнедеятельности)
- Педагогика
- Полиграфия
- Психология
- Салық
- Саясаттану
- Сақтандыру
- Сертификаттау, стандарттау
- Социология, Демография
- Спорт
- Статистика
- Тілтану, Филология
- Тарихи тұлғалар
- Тау-кен ісі
- Транспорт
- Туризм
- Физика
- Философия
- Халықаралық қатынастар
- Химия
- Экология, Қоршаған ортаны қорғау
- Экономика
- Экономикалық география
- Электротехника
- Қазақстан тарихы
- Қаржы
- Құрылыс
- Құқық, Криминалистика
- Әдебиет
- Өнер, музыка
- Өнеркәсіп, Өндіріс
Қазақ тілінде жазылған рефераттар, курстық жұмыстар, дипломдық жұмыстар бойынша біздің қор #1 болып табылады.



Ақпарат
Қосымша
Email: info@stud.kz